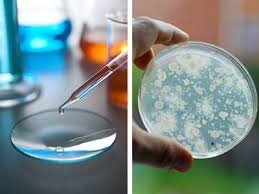

Thermalite (Vermiculite)
Thermalite (Vermiculite) a yellow or brown mineral found as an alteration product of mica and other minerals, used for insulation or as a moisture-retentive medium for growing plants.Thermalite is an environmentally friendly bio stable product. At elevated temperatures, it does not emit any harmful for breathing gases and dust slurries, which is an important advantage compared to other known organic materials, such as rock wool and asbestos.


Thermalite (Vermiculite) is a loose, porous material in the form of scaly particles (silver or yellow), produced in accelerated roasting of Thermalite concentrate (hydromica containing bound water between layers).
Ideal For
- Weathering course
- Landscape
- Seed Germination
- Swimming Pool base
- Pipe Insulation
- Back fill for Fire backs and boilers
- Chimney Lining
- Packaging